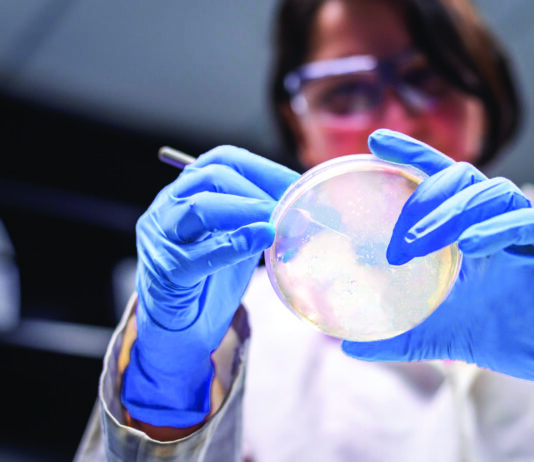
Qiagen überzeugt mit 2025er-Zahlen Symbolbild QIAGEN. S_1232_0_LS_GG_QIAseq_xHYB_Viral_Bacterial_Panels_Launch. Copyright Foto: QIAGEN

„Sie fallen durch alle klassischen Raster – und genau dort sehen wir unsere Rolle.“
Die WLanholding ist eine privat geführte Investmentgesellschaft mit Fokus auf Life Sciences und Sustainability. Gegründet von Werner Lanthaler, investiert sie vor allem in sehr...
Implikationen von IFRS 18 auf Leistungskennzahlen
Bildquelle: © EY
Der neue Rechnungslegungsstandard IFRS 18 beeinflusst die Berechnung und Darstellung der wichtigsten finanziellen Leistungs- und Bewertungskennzahlen im Kapitalmarkt. Dies hat direkte Auswirkungen...
„Der zweite Fonds ist keine Neuausrichtung, sondern die Skalierung eines bewährten Modells.“
CARMA FUND ist ein spezialisierter europäischer Life-Sciences-Tech-Transfer-Fonds. Der Fokus liegt auf sehr frühen Entwicklungsphasen – oft vor oder unabhängig von einer formalen Unternehmensgründung. CARMA...
Asta Energy Solutions mit starkem Börsendebüt
Bildquelle: © ASTA Energy Solutions
Der Energietechnik-Zulieferer Asta Energy Solutions (ISIN: AT100ASTA001) hat am heutigen Freitag ein erfolgreiches Börsendebüt in Frankfurt gefeiert. Zum Handelsstart notierte...
„Wir setzen nicht auf ein einzelnes Pferd, sondern auf das ganze Rennen.“
Die Bundesagentur für Sprunginnovationen SPRIND GmbH agiert dort, wo Grundlagenforschung endet und klassische Investoren noch nicht einsteigen. Mit Validierungsaufträgen, Gründungszuschüssen, Eigenkapitalbeteiligungen, Wandeldarlehen und technologieoffenen...
Thyssenkrupp konkretisiert Spin-Off-Pläne
Bildquelle: © Thyssenkrupp
Mit dem Spin-Off seines Segments Marine Systems (TKMS) im Oktober 2025 hat Thyssenkrupp (ISIN DE0007500001, MarketCap 7,16 Mrd. EUR) einen fulminanten Erfolg...
JPM 2026: Von Modalitäten zu Umsetzung
Auf der J.P. Morgan Healthcare Conference 2026 wurden keine radikalen Technologiesprünge präsentiert – wohl aber klare Zuspitzungen. Nach Jahren breiter Plattformexploration rücken Modalitäten wie...
Positive Bewegung für Anleger im Dieselskandal
Bildquelle: © JT Studio - stock.adobe.com
Im Kapitalanleger-Musterverfahren zum Dieselskandal hat der Bundesgerichtshof (BGH) zentrale Rechtsfragen an den Europäischen Gerichtshof (EuGH) vorgelegt, dies geht aus einer...
Deutsche EuroShop AG
Bildquelle: © Deutsche Börse
Die Deutsche EuroShop AG (ISIN: DE0007480204, MarketCap: 1,4 Mrd. EUR), Deutschlands einzige börsennotierte Gesellschaft, die ausschließlich in hochwertige Shoppingcenter investiert, feiert...
„Wir verbinden frühes Kapital, industriellen Zugang und Erfahrung.“
Der High-Tech Gründerfonds (HTGF) ist einer der führenden und aktivsten Frühphaseninvestoren in Deutschland und Europa für technologieorientierte Startups. Mit öffentlichem und privatem Kapital unterstützt...